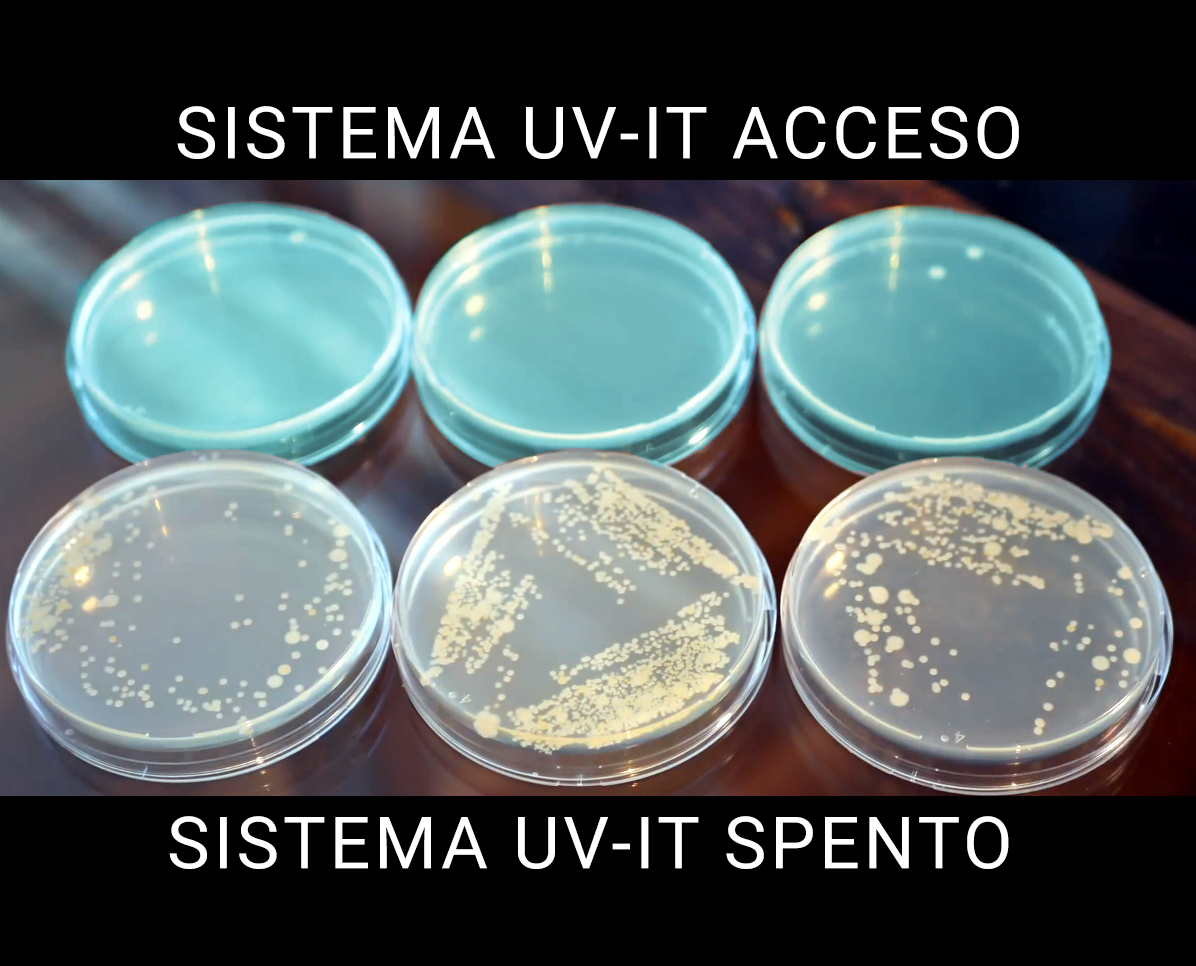

Sanifica in continuo flussi d’aria
Velocità fino a 8 m/s


Lo si installa direttamente sul canale di mandata senza toccare l’UTA
Gestisce alte portate, fino a velocità di 8 m/s
Permette di risparmiare energia, e non usa agenti chimici
Sede di Rovereto
Piazza Manifattura 1
38086 Rovereto (TN) Italy
tel. +39 347 796 6360
Sede di Bologna
Via degli Orti 10
40137 Bologna (BO) Italy
tel. +39 051 0475938